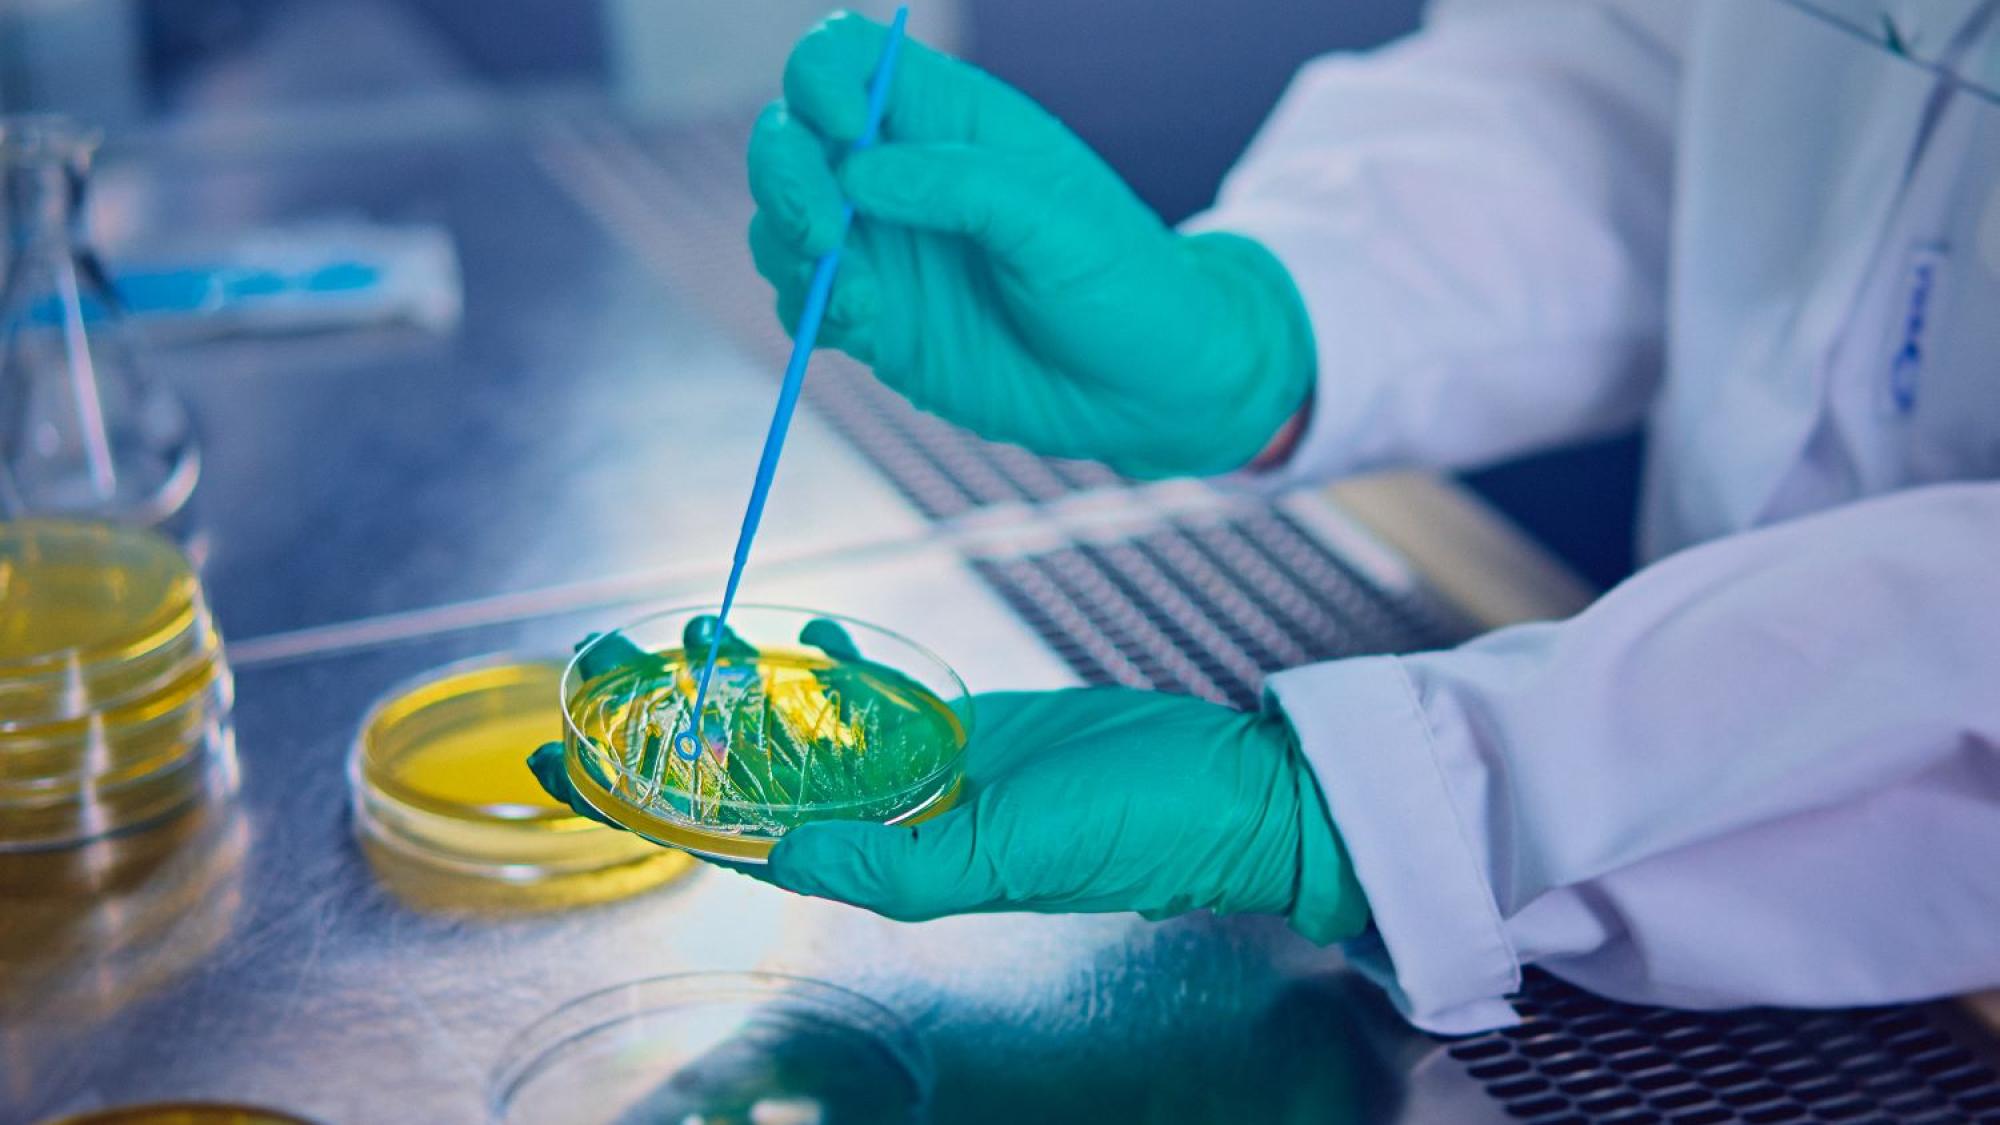

Prosessimallinnus ja synteesi
Tutkimusryhmän tiedot
Yksikkö ja tiedekunta
Yhteystiedot
Yhteyshenkilö
Tutkijat
Tutkimusryhmän kuvaus
Prosessimallinnuksen ja synteesin tutkimuksen fokusalue Kemiallisen prosessitekniikan (CPE) tutkimusyksikössä keskittyy seuraaviin tutkimusalueisiin:
- Ilmiöperustainen prediktiivinen prosessimallinnus erityisesti erotusprosessien aihealueella. Esimerkkeihin lukeutuvat prediktiiviset membraaniprosessimallit ja robustit numeeriset ratkaisustrategiat malleissa.
- Uudenlaisien prediktiivisten laskennallisten työkalujen integroiminen parantamaan prosessisysteemitekniikassa sovellettuja menetelmiä, kuten systemaattisten laskennallisten liuotinseulontamenetelmien yhdistäminen konseptuaalisten prosessien suunnitteluun.
Näitä työkaluja sovelletaan prosesseissa vallitsevien ilmiöiden ymmärtämiseksi ja uusien prosessikonfiguraatioiden suunnittelemiseksi biojalostamokontekstissa. Prosessimallinnustutkimus muodostaa kokonaisuuden yhdessä muiden CPE:n tutkimusalueiden kokeellisen tutkimuksen kanssa.